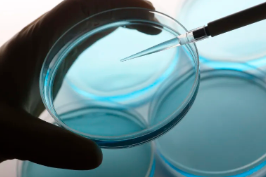
image.png

SCF干細胞具體作用是什么?在治療中有何應用?
2024-11-04 10:58:27 來源: 小編 咨詢醫(yī)生
本文將詳細闡述SCF干細胞的基本概念、作用機制以及在臨床治療中的具體應用,幫助大家更好地了解這一領域的最新研究進展。
SCF干細胞,即干細胞因子(Stem Cell Factor),是一種具有多重生物學功能的細胞因子。在干細胞研究領域,SCF干細胞具有重要作用,它可以促進干細胞的增殖、分化和遷移。下面我們來具體了解一下SCF干細胞的作用及其在治療中的應用。
一、SCF干細胞的具體作用
1.促進干細胞增殖:SCF干細胞可以分裂干細胞在體內的增殖,為組織修復和再生提供足夠的細胞來源。
2.促進干細胞分化:SCF干細胞可以引導干細胞向特定細胞系分化,如神經元、心肌細胞、骨骼細胞等,從而實現(xiàn)組織再生。
3.促進干細胞遷移:SCF干細胞可以促使干細胞向受損組織遷移,加快修復過程。
4.提高干細胞存活率:SCF干細胞可以降低干細胞在移植過程中的死亡率,提高移植效果。
二、SCF干細胞在治療中的應用
1.心血管疾病:SCF干細胞可以用于治療心肌梗死、心肌病等心血管疾病,通過促進心肌細胞的再生和修復,改善心臟功能。
2.神經系統(tǒng)疾?。篠CF干細胞可以用于治療帕金森病、阿爾茨海默病等神經系統(tǒng)疾病,通過替換受損神經元,恢復神經系統(tǒng)功能。
3.骨骼系統(tǒng)疾?。篠CF干細胞可以用于治療骨折、股骨頭壞死等骨骼系統(tǒng)疾病,促進骨骼再生和修復。
4.肝臟疾病:SCF干細胞可以用于治療肝硬化、肝衰竭等肝臟疾病,通過促進肝細胞的再生,改善肝臟功能。
5.皮膚疾?。篠CF干細胞可以用于治療燒傷、創(chuàng)傷等皮膚疾病,促進皮膚再生,減少疤痕形成。
6.免疫系統(tǒng)疾?。篠CF干細胞可以用于治療免疫系統(tǒng)疾病,如系統(tǒng)性紅斑狼瘡、類風濕性關節(jié)炎等,通過調節(jié)免疫系統(tǒng),減輕疾病癥狀。
總之,SCF干細胞在臨床治療中具有廣泛的應用前景。隨著干細胞研究技術的不斷發(fā)展,SCF干細胞在未來的醫(yī)療領域將發(fā)揮更加重要的作用。然而,干細胞治療仍處于初步研究階段,相關治療技術和安全性問題尚需進一步探討。相信在不久的將來,SCF干細胞將為人類健康帶來更多福祉。
- 2024-10-25東陽糖尿病干細胞功效有哪些?治愈率如何?
- 2024-10-29干細胞療法治療睡眠有效果嗎?治療原理是什么?
- 2024-07-31脂肪干細胞治療脫發(fā)過程,脂肪干細胞治療脫發(fā)有用嗎
- 2024-07-21干細胞有什么作用,干細胞作用效果怎么樣
- 2024-11-12干細胞移植治療腎功能衰竭能治愈嗎
- 2024-10-11干細胞治療視網膜脫落未來前景如何?應注意哪些事項?
- 2024-09-04干細胞療法可以治療哪些病,多少錢一針
- 2024-09-17干細胞移植后能生育嗎,對生育影響大嗎
- 2024-08-10臍帶血造血干細胞保存費用
- 2024-08-04乳牙干細胞保存費用,乳牙干細胞怎么保存
- 2024-10-07嘉興肝硬化干細胞功效如何,能否有效改善病情
- 2024-09-20上海打干細胞收費標準詳解
- 2024-09-10遼寧丹東干細胞捐獻機構有哪些
- 2024-07-18淋巴瘤做干細胞移植能痊愈嗎,干細胞移植治療淋巴瘤的作用
- 2024-10-11干細胞治療糖尿病一針要花多少錢?效果能否得到保證?
- 2024-10-12干細胞軟骨修復過程中會疼嗎?如何減輕患者疼痛?
- 2024-09-27貝拉國際醫(yī)療中心是私人機構嗎
- 2024-09-30上海干細胞移植治療肝硬化效果如何,哪些領域適用
